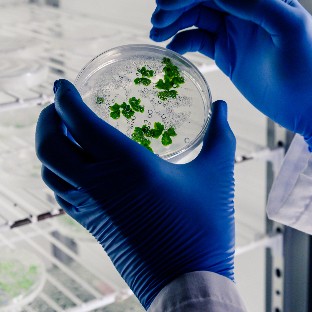

Avalon Screw Dehydrator (ASD)
Avalon Screw Dehydrator (ASD)
Advanced Sludge Dewatering Technology by Avalon Separation
The Avalon Screw Dehydrator (ASD) is a next-generation sludge dewatering solution designed to deliver high efficiency, low operational cost, and reliable performance across industrial and municipal wastewater treatment applications.
Developed with advanced engineering and smart automation, the Avalon Screw Dehydrator (ASD) eliminates common challenges faced in traditional dewatering systems such as clogging, excessive power consumption, high maintenance, and operator dependency.

What is the Avalon Screw Dehydrator (ASD)?
The Avalon Screw Dehydrator (ASD) is a fully enclosed, continuous sludge dewatering system that utilizes a slow-speed screw shaft combined with moving and fixed rings to achieve effective solid-liquid separation.
Unlike belt presses, centrifuges, or filter presses, this technology:
 Operates at very low RPM
Operates at very low RPM Consumes minimal water and electricity
Consumes minimal water and electricity Requires minimal supervision
Requires minimal supervision Offers clog-free operation
Offers clog-free operation
The system gradually increases pressure along the screw shaft, producing high dry solid content with minimal odor and noise.
Advantages
 Low Power Consumption
Low Power Consumption Reduction of investment costs for thickening and storage equipment
Reduction of investment costs for thickening and storage equipment Widely Use
Widely Use Fully Automatic Control
Fully Automatic Control Contactless, Wear Free Structure Design
Contactless, Wear Free Structure Design High Resistance to Oily Sludge
High Resistance to Oily Sludge No skill Worker Required
No skill Worker Required No Fresh Water Cleaning Required
No Fresh Water Cleaning Required No fresh water cleaning required
No fresh water cleaning required Low Maintenance Required
Low Maintenance Required Clog-free
Clog-free Save Running Cost
Save Running Cost Decrease Capital Investment
Decrease Capital Investment Small Footprint
Small Footprint
Why Avalon Screw Dehydrator is Superior
Clog-Free Self-Cleaning Design
The moving and fixed ring structure continuously self-cleans during operation, eliminating blockages and reducing downtime.
Ultra-Low Energy Consumption
Operating at only 2–4 RPM, the system consumes up to 90% less energy than centrifuges and significantly less than belt presses.
No Fresh Water Requirement
Unlike conventional systems, ASD does not require continuous washing water, drastically reducing water consumption.
Compact & Space-Saving Design
Ideal for retrofitting existing plants or installations with space constraints.
Fully Automatic Operation
PLC-controlled automation enables:
 One-touch start & stop
One-touch start & stop Unmanned 24/7 operation
Unmanned 24/7 operation Remote monitoring via SCADA integration
Remote monitoring via SCADA integration
Handles Oily & Fibrous Sludge
Perfect for sludge with high oil, grease, and fiber content.
Key Benefits of Avalon Screw Dehydrator (ASD)
 Low power consumption
Low power consumption Reduced capital investment
Reduced capital investment Minimal maintenance requirement
Minimal maintenance requirement High resistance to oily and sticky sludge
High resistance to oily and sticky sludge No skilled operator required
No skilled operator required Odor-free operation
Odor-free operation Noise-free working environment
Noise-free working environment Long operational life
Long operational life Environmentally friendly process
Environmentally friendly process
Automation & System Integration
The Avalon Screw Dehydrator (ASD) is designed for complete process automation and can be easily integrated with:
 Polymer dosing systems
Polymer dosing systems Sludge feed pumps
Sludge feed pumps DAF systems
DAF systems Conveyors
Conveyors Central PLC & SCADA
Central PLC & SCADA
The system supports:
 Automatic startup & shutdown
Automatic startup & shutdown Alarm management
Alarm management Emergency interruption
Emergency interruption Remote monitoring
Remote monitoring
This ensures maximum safety, reliability, and process optimization.
Direct Dewatering from Oxidation Ditch
Traditional sludge treatment requires pre-thickening before dewatering.
The Avalon Screw Dehydrator (ASD) eliminates this requirement.
Thanks to its advanced filtration structure, it can process sludge with as low as 0.4% solids concentration, enabling direct dewatering from oxidation ditches without additional thickening tanks.
This results in:
 Reduced infrastructure cost
Reduced infrastructure cost Smaller plant footprint
Smaller plant footprint Lower energy consumption
Lower energy consumption
Clog-Free & Odor-Free Operation
The rotating screw shaft causes continuous separation between moving and fixed rings, preventing clogging.
This also ensures:
 No accumulation of solids
No accumulation of solids No secondary pollution
No secondary pollution No unpleasant odors
No unpleasant odors
Ideal for indoor installations and urban environments.
Energy-Efficient Performance
The Avalon Screw Dehydrator (ASD) operates with:
 Power consumption as low as 0.01–0.1 kWh/kg-DS
Power consumption as low as 0.01–0.1 kWh/kg-DS Up to 20× lower energy usage than centrifuges
Up to 20× lower energy usage than centrifuges Up to 8× lower than belt presses
Up to 8× lower than belt presses
This significantly reduces operational expenses and carbon footprint.
Compact Design – Small Footprint
The compact footprint allows installation in areas where traditional systems cannot fit.
It is ideal for:
 Retrofit projects
Retrofit projects Space-restricted plants
Space-restricted plants Mobile treatment systems
Mobile treatment systems
Ideal for indoor installations and urban environments.
Technical Specifications (Indicative)
Throughput depends on sludge characteristics and operating conditions.
| Model | 1% TS (m³/h) | 2% TS (m³/h) | 3% TS (m³/h) | Cylinder | Power (kW) |
|---|---|---|---|---|---|
| ASD-1100 | 0.5 | 0.3 | 0.2 | 100×1 | 0.24 |
| ASD-1150 | 1.0 | 0.6 | 0.4 | 150×1 | 0.37 |
| ASD-1200 | 3.0 | 1.8 | 1.3 | 200×1 | 0.49 |
| ASD-2200 | 6.0 | 3.5 | 2.6 | 200×2 | 0.86 |
| ASD-1300 | 5.0 | 3.0 | 2.1 | 300×1 | 1.0 |
| ASD-2300 | 10 | 6.0 | 4.2 | 300×2 | 2.0 |
| ASD-1400 | 10 | 6.0 | 4.2 | 400×1 | 1.47 |
| ASD-2400 | 20 | 12 | 8.5 | 400×2 | 2.57 |
| ASD-3400 | 30 | 18 | 13 | 400×3 | 3.67 |
| ASD-4400 | 40 | 24 | 16 | 400×4 | 5.14 |
| ASD-1450 | 15 | 9 | 6.5 | 450×1 | 1.87 |
| ASD-2450 | 30 | 18 | 13 | 450×2 | 3.37 |
| ASD-3450 | 45 | 27 | 20 | 450×3 | 5.24 |
| ASD-4450 | 60 | 36 | 25 | 450×4 | 6.74 |
⚠️ Specifications may vary based on sludge composition and site conditions. Please consult Avalon Separation for final model selection.
Applications
The Avalon Screw Dehydrator (ASD) is widely used across multiple industries:

chemical processing plants

dairy & meat processing industries

food & beverage processing units

industrial effluent treatment plants

municipal wastewater treatment plants

oil , gas & refinery sludge treatment
sludge from biological treatment processes

textile & dyeing industries
Why Choose Avalon Separation?
 Over 9+ years of industry expertise
Over 9+ years of industry expertise 130+ successful installations worldwide
130+ successful installations worldwide Proven reliability in harsh environments
Proven reliability in harsh environments Custom-built solutions for every application
Custom-built solutions for every application Strong after-sales service & technical support
Strong after-sales service & technical support Sustainable, eco-friendly engineering approach
Sustainable, eco-friendly engineering approach


